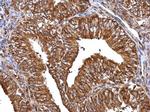
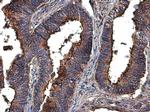
MMP2 Antibody in Immunohistochemistry (Paraffin) (IHC (P))

Search
Invitrogen
MMP2 Polyclonal Antibody
{{$productOrderCtrl.translations['antibody.pdp.commerceCard.promotion.promotions']}}
{{$productOrderCtrl.translations['antibody.pdp.commerceCard.promotion.viewpromo']}}
{{$productOrderCtrl.translations['antibody.pdp.commerceCard.promotion.promocode']}}: {{promo.promoCode}} {{promo.promoTitle}} {{promo.promoDescription}}. {{$productOrderCtrl.translations['antibody.pdp.commerceCard.promotion.learnmore']}}

Please note: We are reviewing Western blot images included in the antibody testing data in our catalog, including those provided by third parties. Unless expressly labeled or annotated as “raw-unedited”, Western blot images included in the antibody testing data in our catalog may have been edited, optimized or otherwise adjusted for presentation.
产品信息
PA5-85197
种属反应
已发表种属
宿主/亚型
分类
类型
抗原
偶联物
形式
浓度
规格
纯化类型
保存液
内含物
保存条件
运输条件
RRID
产品详细信息
Keep as concentrated solution.
Predicted reactivity: Mouse (95%), Rat (95%), Xenopus laevis (81%), Pig (96%), Rabbit (95%), Chicken (85%), Sheep (95%), Bovine (94%).
Positive Control: PC-3, U87-MG, SK-N-SH, U87-MG conditioned medium, mouse brain, DU145.
Store product as a concentrated solution. Centrifuge briefly prior to opening the vial.
靶标信息
MMP (matrix metalloproteinase) are proteolytic enzymes capable of degrading connective tissue components. MMP have a common mode of activation, a conserved amino acid sequence in the putative metal binding-active site region, and are inhibited by specific tissue inhibitors of metalloproteinases (TIMPs). MMPa and TIMPs play a significant role in regulating angiogenesis. MMP2 is synthesized as a 631 amino acid proenzyme which is activated by cleavage of the first 80 amino acids, and contains the basic structure of propeptide, catalytic, and hemopexin domains. The matrix metalloproteinases (MMPs) are a family of at least eighteen secreted and membrane-bound zincendopeptidases. Collectively, these enzymes can degrade all the components of the extracellular matrix, including fibrillar and non-fibrillar collagens, fibronectin, laminin and basement membrane glycoproteins. In general, a signal peptide, a propeptide, and a catalytic domain containing the highly conserved zinc-binding site characterizes the structure of the MMPs. Functionally, MMP2 is involved in tissue remodeling. Mutations in MMP-2 gene have been associated with Winchester syndrome and Nodulosis-Arthropathy-Osteolysis (NAO) syndrome. Two transcript variants encoding different isoforms of MMP-2 have been found.
仅用于科研。不用于诊断过程。未经明确授权不得转售。
生物信息学
蛋白别名: 72 kDa gelatinase; 72 kDa type IV collagenase; 72kD gelatinase; 72kD type IV collagenase; 72kDa gelatinase; 72kDa type IV collagenase; CLG 4A; Collagenase; Gelatinase A; Gelatinase alpha; Mat; matrix metallo protease; matrix metallopeptidase 2 (gelatinase A, 72kDa gelatinase, 72kDa type IV collagenase); matrix metalloproteinase; matrix metalloproteinase 2; Matrix metalloproteinase-2; MMP; MMP-2; MMPs; Progelatinase A; TBE-1; TBE1
基因别名: CLG4A; GelA; MMP-2; MMP2
UniProt ID: (Rat) P33436, (Mouse) P33434
Entrez Gene ID: (Pig) 397391, (Rat) 81686, (Mouse) 17390



